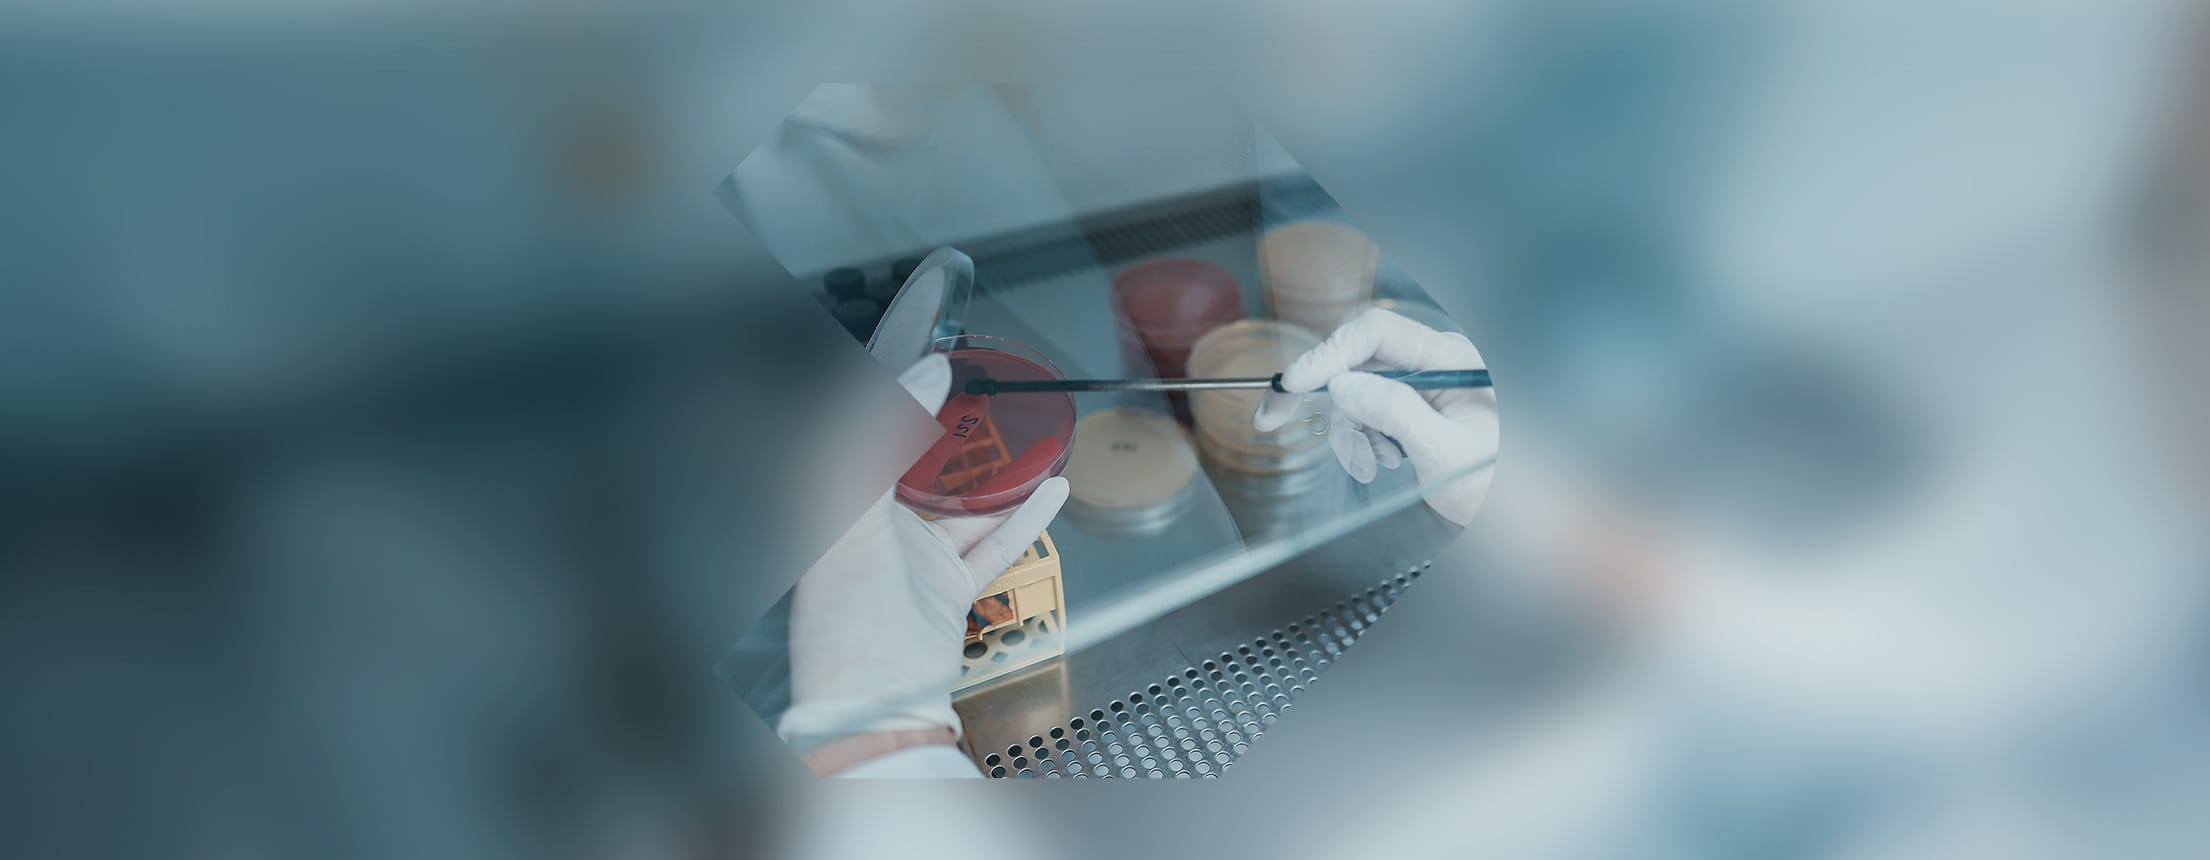

Microbiology & Analytical Services
Our Microbiology & Analytical Services safeguard product purity through ISO 17025-accredited preservative efficacy (challenge) testing, total viable count (TVC) assays, and pathogen screening for critical organisms (e.g., Staphylococcus aureus, E. coli, Candida albicans).
ContactWe also specialise in a comprehensive heavy metal test suite and residual solvent detection, ensuring trace contaminants remain below regulatory thresholds. For cannabinoid-infused products, advanced HPLC methods precisely quantify CBD or THC content, providing essential validation for manufacturers. In-house physico-chemical analysis, including a precise pH test, water activity, and flash point assessment, helps confirm consistency and compliance across diverse formulations. Whether you are developing cosmetics, household cleaners, or emerging novel foods, our team delivers fast, accurate insights that minimise risks and streamline product release. By prioritising quality and safety at every stage, we empower you to stand out in increasingly regulated global markets with robust heavy metal test data and formulation assurance.
Testing solutions
- Veterinary Laboratory Services
- Ecotoxicology & Environmental Testing
- Environmental Fate & Biodegradation
- Analytical Chemistry & Dose Verification
- Bespoke & Custom Studies
- Stability & Compatibility Testing
- Microbiology & Analytical Services
- Consumer & Clinical Testing
- Materials Testing
- Fire Resistance Testing
What our clients have to say
Latest news & insights
Explore all newsSpeak to Our Specialists
Our experienced team is here to support you with expert testing, inspection, compliance, and assurance services.
Get in touch to discuss your requirements.





